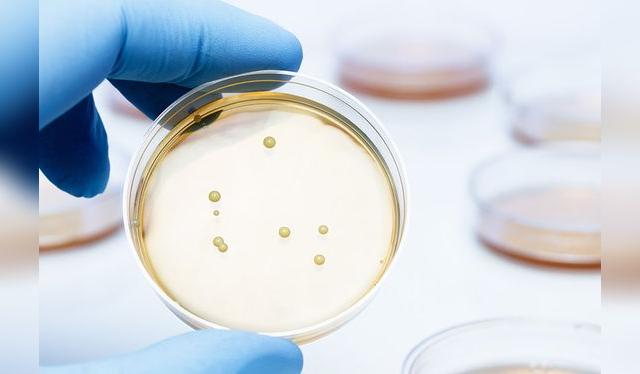
Cultivo de <em>Lactobacillus bulgaricus</em> que se usa para la elaboración de yogur.

Yogur: Tipos y usos
Aprende a reconocer los distintas variedades de yogures y sus usos en la cocina.

El yogur es un alimento que ha ganado terreno en nuestra dieta diaria. En la actualidad, muchas personas suelen consumirlo en el desayuno; sin embargo, sirve también como ingrediente de distintos platos y postres. Por esa razón, es importante identificar sus distintas variedades, así como sus múltiples aplicaciones en la cocina. ¡Veamos!
Únete a nuestro canal de WhatsappEl yogur es un producto lácteo que contiene cultivos de bacterias vivas (las más comunes son Lactobacillus bulgaricus y Streptococcus thermophilus). Estas bacterias funcionan como probióticos en beneficio de nuestra flora intestinal y también llamadas microbiota. Básicamente, lo que hacen los probióticos o cultivos bacteriales es lograr la fermentación de la leche, transformando su azúcar (lactosa) en ácido láctico; lo que le da su consistencia espesa y su acidez características.
¿Cómo reconocemos un yogur auténtico?
La manera más simple es por su ubicación en los mercados y supermercados: los yogures necesitan refrigeración, para que los cultivos bacteriales se mantengan vivos y activos. Los auténticos yogures tienen mayores beneficios para la salud que aquellos que no contienen bacterias vivas. Así pues, si no están en un espacio refrigerado, pueden ser bebidas lácticas, pero no yogures. Una vez que identifiques su ubicación, debes revisar el etiquetado para confirmar.

Tipos de yogur
Si nos fijamos en el supermercado, veremos que hay muchos tipos de yogures pero todos parten de 2 tipos básicos: el natural y el griego. A partir de esta división aparecen las variantes: con o sin azúcar añadida, con o sin frutas, con leche entera o descremada (entre 3.5% y 0.5% de grasa) y los saborizados.
Los yogures bebibles simplemente tienen más leche y han sido batidos para hacerlos más cremosos. Además, algunos productos tienen nutrientes añadidos, como vitaminas, minerales, e incluso probióticos. Veamos qué diferencia al yogur natural del griego.

Yogur natural vs yogur griego
El yogur natural es también llamado tradicional. Se caracteriza por su sabor agrio, ligeramente ácido, y su consistencia cremosa; que es aun mayor en el caso del griego, ya que requiere más leche. Ambos son una excelente fuente de calcio y potasio, que son buenos para nuestros huesos y salud arterial. La principal diferencia entre el natural y el yogur griego es que el segundo es más concentrado. Es decir, se le ha eliminado líquido. Por esta razón, tienen mayor concentración de proteínas, carbohidratos y calorías; pero menos calcio. Las personas con intolerancia a la lactosa, por ejemplo, suelen digerir mejor el yogur griego.

¿Cómo se usan en cocina?
El yogur es un alimento súper versátil. Además de consumirse puro, puede usarse tanto para platos fríos como calientes, y dependen mucho de su contenido de grasa. Si es alto en grasa, puede incluso reemplazar una crema de leche. Al ser más denso, el yogur griego se integra mejor a las preparaciones: queques, aliños o vinagretas, helados… El yogur natural, al ser más líquido, es mejor para beberlo, pero puede usarse para aliños de ensalada o variantes de mayonesa.

¿Y qué son el kéfir y el skyr?
Técnicamente, el kéfir no es un yogur, aunque también se trata de un fermento lácteo que contienen cultivos bacteriales vivos beneficiosos para la salud. Estos cultivos se obtienen de los granos de kéfir (parecido al brócoli) en contacto con la leche (a un temperatura más baja que la que requiérete el yogurt), lo que produce una bebida fermentada y ligeramente carbonatada, más líquida que el yogur natural.

El skyr, por su parte, también es un producto lácteo fermentado, típico de Islandia, pero tiene menos contenido graso debido a que se hace con leche descremada. Además, tiene un proceso ligeramente distinto al yogur, por lo que resulta en un producto distinto.
Y a ti, ¿qué tipo de yogur te gusta?




















